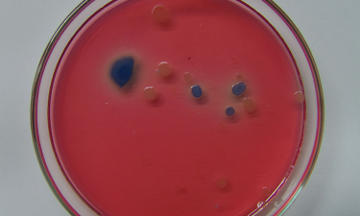
Laboratorio CIC - Análisis bacteriológicos

Bacteriología

Realizamos análisis bacteriológicos en aguas y efluentes líquidos, de uso doméstico o industrial. También podemos realizar la toma de muestra de las mismas de acuerdo a la normativa establecida (EPA, WHO).




Realizamos análisis bacteriológicos en aguas y efluentes líquidos, de uso doméstico o industrial. También podemos realizar la toma de muestra de las mismas de acuerdo a la normativa establecida (EPA, WHO).